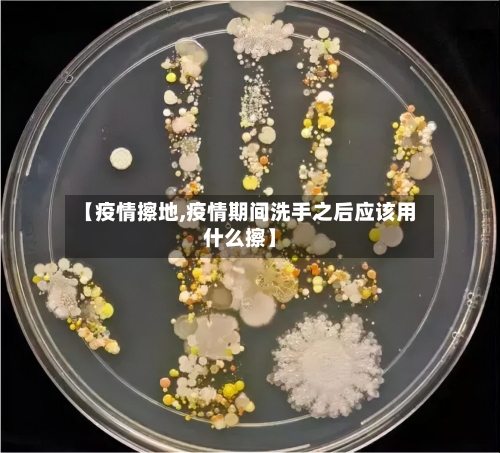
【疫情擦地,疫情期间洗手之后应该用什么擦】-第2张图片

〖壹〗、强化地板可以使用拖把 、抹布、清洁剂、杀菌剂 、地板蜡、光洁剂,以及女同志不穿的丝袜配合木质地板专用清洁剂进行擦洗。以下是具体的擦洗方法和建议:拖把和抹布:拖把和抹布是日常清洁强化地板的常用工具 。使用前 ,确保拖把和抹布干净且微湿,避免使用过多水分,以免地板受潮膨胀。

〖贰〗、强化地板可以使用拖把 、抹布、清洁剂、杀菌剂 、地板蜡以及光洁剂等进行擦洗。以下是具体的擦洗方法和注意事项:基本擦洗工具 拖把:选取质地柔软、吸水性好的拖把 ,避免使用硬毛或金属丝的拖把,以免划伤地板表面 。抹布:柔软的抹布可以用于擦拭地板上的污渍和灰尘,特别是难以用拖把清理的边角区域。
〖叁〗、拖把:使用拖把可以方便地大面积清洁强化地板 ,是日常清洁的常用工具。抹布:对于局部顽固污渍或难以清理的区域,可以使用抹布进行细致擦拭 。清洁剂:选取适合强化地板的专用清洁剂,能够更有效地去除污渍 ,同时保护地板表面。
〖肆〗、强化地板可以使用拖把 、抹布、清洁剂、杀菌剂 、地板蜡以及光洁剂等工具进行擦洗。以下是具体的擦洗方法和注意事项:拖把与抹布:拖把:选取质地柔软、吸水性好的拖把,避免使用硬质或粗糙的拖把,以免划伤地板表面 。抹布:同样需要选取柔软且不掉毛的抹布,用于擦拭地板的边角和细节部分。
〖壹〗、疫情期间选取有效的消毒剂和消毒方式需综合考虑消毒效果 、安全性、便捷性及家庭使用特点 ,推荐优先选取二氧化氯消毒剂并配合性能可靠的喷壶进行喷洒消毒,同时根据具体场景合理选用其他消毒方式。
〖贰〗、空气消毒:建议每天尽量开门窗通风,次数不少于2~3次 ,每次通风时间不少于半小时。这有助于降低室内病毒浓度,减少感染风险 。个人小件用品:对于钥匙 、手机等个人小件用品的外表面,可以采用棉球蘸取医用酒精进行擦拭 ,或使用消毒湿巾擦拭。
〖叁〗、后疫情时代,应采用科学、安全的清洁方式,避免因不当使用消毒剂而造成“投毒”风险 ,推荐采用五维清洁维护方式。消毒剂使用不当的风险:消毒剂虽能有效杀死体外表面的微生物,但它们是剧毒的化学物质 。注射或摄入消毒剂,毒害或杀死人体的可能性远远大于毒害或杀死病毒的可能性。
〖肆〗 、做好共享区域卫生:卫生间、浴室等共享区域要特别注意通风和消毒。这些区域相对封闭且潮湿 ,容易滋生细菌和病毒,定期通风和消毒可有效预防病毒传播 。注重手部卫生:自己准备食物、饭前便后、戴口罩前后,都应当洗手或进行手消毒。擦手时,比较好使用一次性擦手纸 ,避免交叉感染。
〖伍〗 、疫情期间安全有效地给办公室消毒的方法如下:使用84消毒液:稀释比例:将84消毒液与水按照1:100的比例稀释 。操作方法:将稀释后的消毒液装入喷壶,均匀地喷洒在办公室的各个表面。注意事项:84消毒液中的次氯酸钠成分可能具有腐蚀性,操作时务必戴上塑料手套以保护双手。
〖陆〗、面对疫情 ,采用紫外线+臭氧的消毒杀菌方式最靠谱 。在疫情期间,为了有效隔离病毒,保障家庭卫生安全 ,选取合适的消毒杀菌方式至关重要。

〖壹〗、洒哇地咔在清洁拖把领域经历了从传统拖把到电动擦地、吸擦一体 、吸擦洗一体洗地机,再到蒸汽拖把的革命历程,具体如下:从传统拖把到电动擦地背景:拖把起源无从考证 ,传统拖把一般由一根木棍和一些碎布条捆绑而成。
〖贰〗、定期清洁电动拖把清洁拖布:每次使用后,及时取下拖布进行清洗。对于可机洗的拖布,按照说明书要求放入洗衣机清洗;对于不可机洗的拖布 ,可用手搓洗,然后用清水冲洗干净,晾干后再安装回电动拖把 。清理机身:定期用干净的湿布擦拭电动拖把的机身,去除灰尘和污渍。
〖叁〗、高频擦地:擦地频率同样可达1000次每分钟 ,清洁效果显著。LED照明:自带LED灯,方便清洁黑暗角落 。一键喷水:内置喷水装置,喷水拖地两不误 ,使用便捷。综上所述,洒哇地咔的X3电动拖把 、K660吸尘器、KC301除螨仪以及D260擦地机都是性价比高的产品,具体选取哪一款还需根据个人家庭的实际需求和预算来决定。
〖肆〗、首先是洒哇地咔X3 ,这款电动拖把是和洒哇地咔K660吸尘器的完美搭档 。它集打蜡 、干拖和湿拖于一体,特别适合在家带娃或者懒癌患者以及腰不好不适宜做家务的女生。清洁力极强,每分钟可达1000次的擦地频率 ,操作起来声音也很小,不会打扰到休息。
〖伍〗、苏泊尔(SUPOR)推荐产品:苏泊尔电动拖把无线拖地机洗拖一体全自动拖布喷水拖把手持擦地机往复式洗地机 特点:苏泊尔作为知名家电品牌,其电动拖把以高效、便捷著称 。无线设计摆脱了电源线的束缚 ,让清洁更加自由。自动喷水、往复式擦地等功能,提升了清洁效率和质量。
〖陆〗 、追觅(dreame)H12Pro无线智能洗地机吸拖洗除菌一体擦地机全自动家用电动拖把手持吸尘器扫地 H12 Pro 追觅家用洗地机 吸洗拖一体拖地机擦地机H12 S电解水除菌热风自烘干 无线智能吸尘器 石头:国产清洁品牌,产品覆盖吸尘器和洗地机 。
家务负担过重会成为家庭矛盾的导火索,而通过科技工具优化家务流程可显著减轻压力 ,提升家庭生活质量。家务矛盾的根源:时间与精力的双重透支情绪积累:疫情期间家庭成员长时间共处,家务分工不均易引发负面情绪。例如文中妻子因长期承担繁重家务,最终因心理崩溃而爆发矛盾。隐性付出:家务的“时间成本 ”常被忽视 。
有了宝宝之后 ,家务...大概是我们每天除了工作带娃之外,最耗心力的一件事情了吧!甚至有人说过,家务是压垮我们成年人体面生活的最后一根稻草。是啊 ,为了保持家里面的干净整洁,我们经常要花费大量的时间,付出很多的心力 ,因为每天都有擦不完的灰尘,收拾不尽的物品。
故事内容如下:一个主人有一匹老骆驼,它一天到晚任劳任怨地干活 ,有一次主人想看看这个老骆驼到底还能拉多少货物,于是不断地加、不断地加,但是老骆驼还是没有倒下,最后主人想是否已经到了极限呢 ,于是轻轻地投了一根稻草在它背上,没想到就是这一根稻草使老骆驼轰然倒下 。
家务权责模糊:压垮日常的最后一根稻草 现实中,约68%的夫妻矛盾因家务分配爆发。例如男方认为“做饭带娃是女人的事” ,女方被迫承担90%家务且得不到认可;或一方嘴上说“共同承担”,但实际行动推脱拖延。
压垮女人的最后一根稻草,通常不是突如其来的巨大打击 ,而是那些看似微不足道,却日积月累的小事 。 在生活的重压下,女性常常身兼数职 ,她们是职场上的斗士,家庭中的支柱,以及情感的避风港。 这些不断的角色转换和责任担当 ,使得她们肩上的负担逐渐加重。
〖壹〗、没有消毒液用什么代替擦地 可用苏打水代替擦地 。苏打水也具有杀菌消毒的效果,医院也经常会用它作为外用消毒。可以在清水中加入一定量的小苏打,让它充分溶解,然后用此溶液擦地 ,还可以用来擦拭家具等。家里消毒需要注意哪些问题 消毒液的选取 如今超市的消毒液琳琅满目,品牌和种类非常多,它们的成分不一样 ,适用的对象也不一样 。
〖贰〗 、洗衣粉。如果没有消毒液的话,可以使用洗衣粉溶解到擦地的水中,效果是一样的 ,但要注意洗衣粉的量不要太大,否则如果没有晾干会容易很滑。面碱水。特别是厨房,较好使用碱的水来擦地就比较好 ,较简单的办法就是用两勺面碱溶解到擦地的水中,而且擦地的时候水要用热水 。
〖叁〗、使用洗衣粉:若没有消毒液,可将洗衣粉溶解于擦地水中 ,效果与消毒液类似。但要注意洗衣粉用量不宜过多,否则地面未晾干时会比较滑。使用面碱水:厨房地面适合用碱性水擦洗,可将两勺面碱溶解于热水中,用此水擦地 。热水配合面碱去污能力强 ,能防止厨房污渍在瓷砖表面停留。
〖肆〗、如果没有滴露消毒液,完全可以用家中常备的医用酒精 、84消毒液等进行有效替代。理解了替代的必要性后,我们来看看这些常见的替代品各自的特点和最佳使用场景 。 医用酒精医用酒精的核心成分是乙醇 ,它能通过让细菌或病毒的蛋白质变性来达到消毒目的。
〖伍〗、适用场景:在没有消毒液的情况下,可以选取使用洗衣粉。操作步骤:将少量洗衣粉溶解在擦地用的水中,注意洗衣粉的量不宜过大 ,以免地面未晾干时变得过滑 。用拖把蘸取洗衣粉溶液拖地,同样可以达到清洁的效果。 使用面碱水清洁(特别是厨房)适用场景:厨房等油污较重的区域。
〖陆〗、家里的瓷砖地面用什么清洁好1 消毒液 。如果家里的瓷砖全面积比较大的话,那每天擦地的时候 ,比较好用84消毒液溶解到擦地的水中,然后去擦地,这样的话会死瓷砖 ,表面光亮,而且空气比较清新干净。